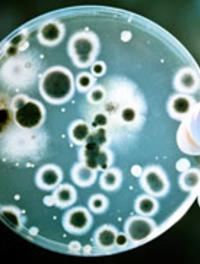
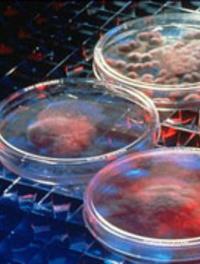

De nouvelles recos pour traiter les cœurs trop gros
Heart Failure 2016
Du 21/05/2016 au 24/05/2016
- Florence

Couplé avec le 3ème congrès mondial sur la défaillance cardiaque aiguë, le congrès Heart Failure 2016 (Florence 21-24 mai) a réuni [...]